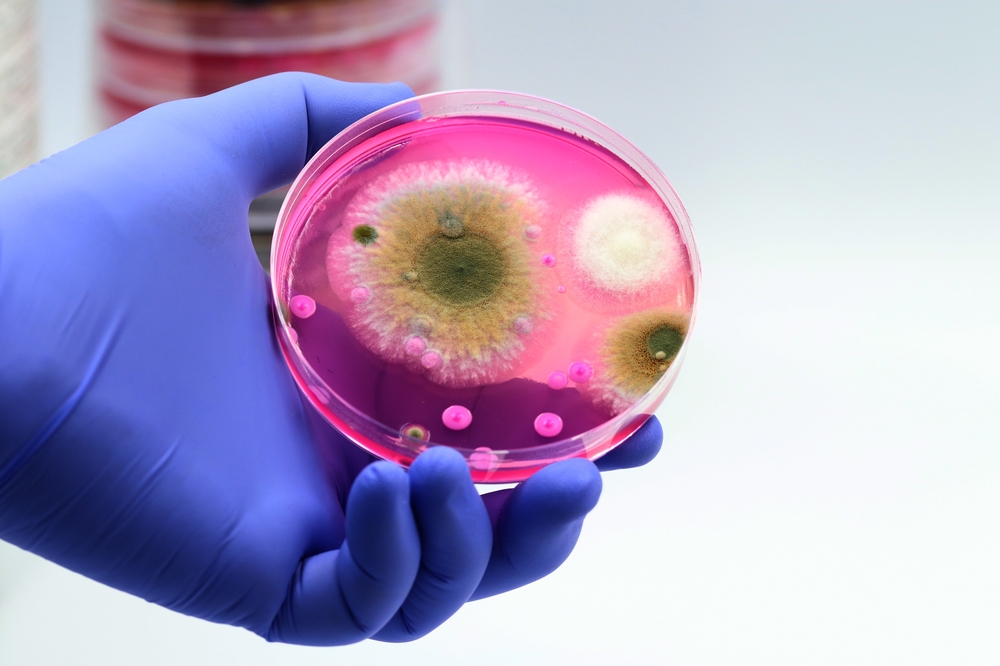
gljivice, gljivica, infekcija

Znanstvenici na dobrom putu razviti prvo cjepivo protiv fatalnih gljivica
Za sada ne postoji odobreno cjepivo za gljivične infekcije, ali se znanstvenici nadaju da će njihov rad uroditi plodom.
Znanstvenici razvijaju cjepivo za koje se nadaju da bi mogao biti prva imunizacija za borbu protiv invazivnih gljivičnih infekcija. Iako je do sada testirana samo na životinjama, istraživanje bi na kraju moglo utabati put cjepivu širokog spektra koja bi se mogao uhvatiti u koštac s rastućom prijetnjom gljivica otpornih na lijekove, piše IFL Science.
U nedavnoj studiji eksperimentalno cjepivo je dizajnirao da zaštiti od tri najčešća uzročnika gljivičnih infekcija – Aspergillus, Candida i Pneumocistis – koji su odgovorni za više od 80 posto smrtonosnih gljivičnih infekcija.
Eksperimenti Sveučilišta u Georgiji su pokazali da glodavci i primati, koji su primili cjepivo, imaju znatno veće šanse za preživljavanje u usporedbi s necijepljenim životinjama.
Ovaj uspjeh je potvrđen dokazima koji su pokazali da je cjepivo bilo efikasno u razvoju zaštitnih antitijela protiv sva tri gljivična patogena.
"Kako cilja na tri različita patogena, cjepivo ima potencijal postati revolucionarno u pogledu invazivnih gljivičnih infekcija", rekla je Karen Norris, vodeća znanstvenica i profesorica na Fakultetu veterinarske medicine. Dodala je da su u toku planovi za razvoj cjepiva koje bi se koristilo za ljude. U pitanju je prva faza u kojoj se ispituje njena sigurnost.
Trenutno nema odobrenih cjepiva za gljivične infekcije, a zabrinutost zbog prijetnje gljivičnih infekcija otpornih na lijekove raste.
Novi eksperimentalni tretmani su u toku, ali je jasno da svijet nije spreman za porast gljivičnih infekcija otpornih na lijekove.
Prva linija obrane od ljudskih gljivičnih infekcija je obično liječenje azolima, koji su antifungalni lijekovi širokog spektra. Međutim, sve je veći broj slučajeva takozvanih supergljivica koje su razvile otpornost na ove lijekove zbog prekomjerne upotrebe antifungalnih aktivnih tvari.
Na primjer, 2021. godine, otkriveno je da se gljivične infekcije otporne na lijekove koje su bile potpuno otporne na sve glavne klase antifungalnih lijekova, po prvi put šire među hospitaliziranim pacijentima u SAD-u.
Znanstvenici širom svijeta su također prijavili porast "lukavih" gljivičnih infekcija među pacijentima s covidom-19 tijekom pandemije.
Tko je u rizičnoj skupini?
Glavna skupina ljudi u riziku su oni s oslabljelim imunološkim sustavom, posebno ako borave u bolničkom okruženju gdje se infekcije mogu širiti poput požara. Za ove ljude cjepivo koja štiti od invazivnih gljivičnih infekcija, ima potencijal postati spasonosno.
Međutim, kako je liječenje još uvijek u ranoj fazi testiranja, proći će neko vrijeme prije nego što ovo cjepivo postane korisno za pacijente.
"Ovo je područje koje je dugo bilo nedovoljno razvijeno na polju istraživanja", dodala je Norris, koja je također istaknuta znanstvenica iz Saveza za istraživanje u području imunologije i translacijske biomedicine u Georgiji.
Dodala je da je velika populacija ljudi koji su u opasnosti od invazivnih gljivičnih infekcija, i iako su uloženi značajni napori u razvoj cjepiva, nijedno još nije odobreno.
"Vjerujemo da je ovo jak kandidat za cjepivo", rekla je znanstvenica.
Studija je objavljena u časopisu PNAS Nexus u studenom 2022.
N1 pratite putem aplikacija za Android | iPhone/iPad i društvenih mreža Twitter | Facebook | Instagram.
Kakvo je tvoje mišljenje o ovome?
Pridruži se raspravi ili pročitaj komentare